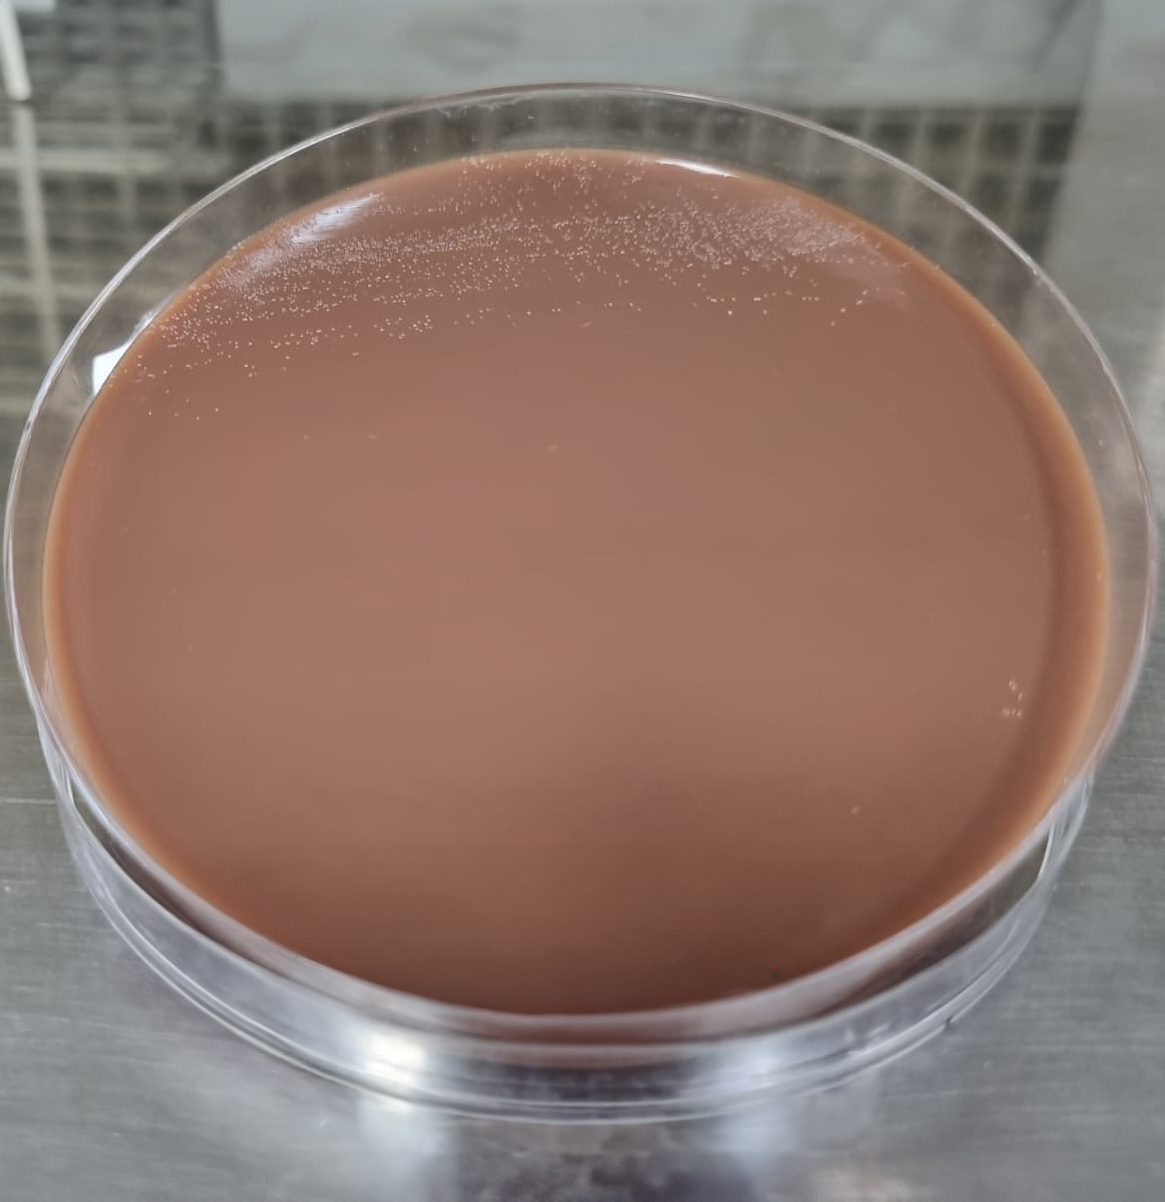

Neisseria gonorrhoeae
Les presentamos el siguiente caso: Paciente masculino de 37 años que consulta por secreción anal y sensación de pujo, posterior a una relación sexual sin protección ocurrida dos semanas antes del inicio de los síntomas.
El médico solicita cultivo para Neisseria gonorrhoeae. En el laboratorio se realiza hisopado rectal y la muestra es sembrada en agar sangre y agar Thayer Martin, incubados en atmósfera enriquecida con CO₂ al 5% a 35 °C. Tras 24 horas de incubación se observan colonias pequeñas, grises y mucosas, con fermentación de glucosa.
La coloración de Gram evidencia diplococos Gram negativos con la característica morfología en “grano de café” y prueba de oxidasa positiva. La identificación se confirma mediante el sistema automatizado VITEK® 2, obteniendo una identificación excelente de Neisseria gonorrhoeae.
En las imágenes se aprecia el crecimiento del microorganismo en agar Thayer Martin y su aspecto microscópico característico.